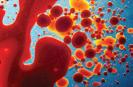

2023 Registration Renewal Advanced Foot Care
Judgment: HARM REDUCTION ISSN 1920-6348 CARE VOLUME 36 ISSUE 2 • FALL/WINTER 2022
Caring Without



2 care | VOLUME 36 ISSUE 2
Copyright © 2022 College of Licensed Practical Nurses of Alberta

CARE is the official publication of the College of Licensed Practical Nurses of Alberta (CLPNA), published on a biannual basis beginning in 2021. Reprint or copy of any content in whole or in part requires consent from the CLPNA Communications Department.
Editorial services provided by: Bird Communications.
Graphic Design by: Tim Abel, Graphic Overload.

Signed articles represent the views of the author and not necessarily those of the CLPNA.
The CLPNA has final discretion regarding the acceptance of notices, courses or articles and the right to edit any material. Publication does not constitute CLPNA endorsement of, or assumption of liability for, any claims made in advertisements.
Working Towards a More Diverse, Equitable, and Inclusive Culture


COVER STORY Caring Without Judgment: Harm Reduction
Harm reduction is something LPNs do every day, by educating, providing support or referrals, and building relationships. Reducing harm for people who use substances supports public health, and is founded on kindness, caring and compassion.
Stigma - Why Words Matter
care | FALL/WINTER 2022 3
contents
4 | 6 | 14 | 26 |
FALL/WINTER 2022
Standards of Practice: Why Are They So Important? Council Update: New Public Member 2023 Registration Renewal Changes Coming to Registration Dates in 2024 Study with CLPNA Understanding HCA Regulation
28 | 32 | 9 | 5 | 18 14 32 28 8 | 36 | 12 | 18 |
RESEARCH The Relationship Between Work Environment and Nurse Health Foot Care: Every Nurse's Responsibility Basic Mouth Care Caring for Those With Dentures/False Teeth/No Teeth
Standards of Practice: Why Are They So Important?
Have you ever wondered why standards of practice are so important? While the answer might seem obvious, the importance of standards of practice is worth a closer look.
Standards of practice are necessary to establish legal and professional expectations and accountability in nursing. Nurses follow standards of practice in their clinical decisions and actions. Standards of practice help nurses maintain their individual competence and currency in practice over the course of their careers. As a framework for professional practice, standards of practice promote safe, competent, and ethical care to support the best possible outcome and minimize the risk of harm to patients.
The Canadian Council for Practical Nurse Regulators (CCPNR) is a national federation of provincial and territorial regulators of Licensed/Registered Practical Nurses. In 2020, CCPNR collaborated to update the practical nursing profession’s Standards of Practice.
The College of Licensed Practical Nurses of Alberta (CLPNA) has adopted the 2020 CCPNR Standards of Practice to guide the practice expectations and accountabilities for Licensed Practical Nurses (LPNs) practicing in Alberta. LPNs have the professional responsibility to become familiar with these standards and the related principles as they are accountable to meet them in practice.
So, why are standards of practice so important?
Standards of practice provide the benchmarks against which the CLPNA assesses Alberta LPNs. There are four standards all LPNs should be aware of. These include professional accountability and responsibility, evidence informed practice, public protection through self-regulation, and professional and ethical practice. Each standard has several indicators that provide more detail as to how the LPN is expected to meet that standard. These standards provide the foundation to support quality LPN practice.
Be in the know! As an LPN, your practice and the quality of care you provide depends on it!
The 2020 CCPNR Standards of Practice and the accompanying Glossary of Terms are available on the CLPNA website
Questions? Contact the CLPNA Practice Team at practice@clpna.com, 780-484-8886 or 1-800-661-5877 (toll-free in Alberta).
4 care | VOLUME 36 ISSUE 2
Council Update: New Public Member

The College of Licensed Practical Nurses of Alberta is excited to announce the appointment of a new public member to the CLPNA Council.
In June, Colleen Sekura was appointed as a public member by the Government of Alberta for a 3-year term to support public protection through regulation. Colleen currently works as the Executive Director for the Drayton Valley Health Services Foundation and is a licensed real estate broker. Colleen brings over 24 years of experience volunteering on various boards and committees, including as secretary to the Drayton Valley & District Agricultural Society (1998 – 2015) and the Yellowhead Conservative Association (2003-2016). She has a strong sense of community and participates actively in numerous non-profit organizations.
“Public representatives on the CLPNA’s Council are committed to transparency in the regulation of LPNs in Alberta,” states Kurtis Kooiker, President of CLPNA Council. “Their role is to act on behalf of Albertans on the Council to support the CLPNA to regulate the LPN profession with public protection at the centre of every decision. Colleen brings a wealth of knowledge and experience as a public member on the Council. We are looking forward to her insight and diverse perspective, which will benefit the work the Council is doing over the next year.”
About Council
Council members are responsible for the governance of the CLPNA and the oversight of the CLPNA’s management of its business and affairs. The Council is the governing body of the CLPNA. It comprises six public and six regulated members, bringing different perspectives and experiences together to provide strategic direction to the CLPNA. Public representatives on the CLPNA’s Council are committed to transparency in the regulation of LPNs in Alberta.
Learn more about Council and its members on the CLPNA website
Questions? For more information, contact info@clpna.com, 780-484-8886 or 1-800-661-5877 (toll-free in Alberta).

care | FALL/WINTER 2022 5
iStock.com/hxdbzxy
2023
• work in Alberta as a Licensed Practical Nurse in 2023 (with Active registration type)
• OR cancel their practice permit and notify the CLPNA they are not renewing for 2023
For complete info, see www.CLPNA.com, “Members”, “Registration Renewal”.
DEC.
Annual LPN Registration Renewal begins October 1, 2022, for the 2023 year. The CLPNA encourages all LPNs to renew before December 1 to pay the lowest registration fee of $350. For those who miss the December 1 deadline, the renewal fee increases to $550 when submitted between December 2 to 31. Formal notices will be sent by email.
PRACTICE HOURS REQUIREMENT FOR 2023
For renewal for 2023, all Licensed Practical Nurses will be required to have provided nursing services for a minimum of 1000 hours within the previous four-year period (2019 - 2022) to be eligible for registration. This practice hours requirement will not apply to recent graduates who have been graduated for fewer than four years. Those LPNs who do not qualify for renewal may be eligible for the Refresher Program for LPNs.
Practical nurse Refresher Programs support a return to practice for individuals previously registered with the CLPNA on the general register but who are no longer eligible for active registration. To read more on the Refresher Program, please review the Membership Policy: Refresher Program

6 care | VOLUME 36 ISSUE 2
CLPNA members must successfully complete the annual Registration Renewal process in order to:
SUBMIT BY
REGISTRATION RENEWAL iStock.com/g-stockstudio
1 2022
DO NOT LET YOUR PRACTICE PERMIT EXPIRE
Only those with a valid CLPNA Practice Permit are authorized to work as an LPN in Alberta or use the title ‘Licensed Practical Nurse’ as stated in Schedule 10 of the Health Professions Act
The repercussions of working with an expired or invalid practice permit are serious and impact both an LPN’s registration and disciplinary status. The process to become reinstated may take weeks and involves the CLPNA’s Registration and Complaints departments. Fees totalling $1280 must be paid, including $780 in Practice Permit fees, and a $500 Complaints fee will be charged if the LPN practices on an expired license.
MATERNITY, LEAVES AND CANCELLATION
Maternity or Short-Term Leave?
The CLPNA recommends LPNs renew for an Active Practice Permit to return to work without delay for those taking shortterm or maternity leave.
Retiring or Not Renewing?
To cancel registration completely, LPNs should select the “Change My Registration” option on their myCLPNA account. This will capture final information about the LPN’s practice hours and demographic information. Until the Registration Renewal form is submitted, LPNs will continue to receive reminders, and suspension and cancellation notices as required by the Health Professions Act
PREPARING TO RENEW
To begin the 2023 Registration Renewal application, login to www.myCLPNA.com directly, or go to www.clpna.com and in the upper right corner, click on the blue “myCLPNA Login” graphic.
BEFORE BEGINNING, GATHER:
Your www.clpna.com password.
Your nursing practice hours. Count hours from Jan. 1, 2022 to the submission date of your Renewal application. Then, add your estimated practice hours from that date to Dec. 31, 2022. For guidance, see the Policy: Actively Engaged Requirements for Registration and the Continuing Competence Program and the Nursing Practice Self-Assessment Tool.
Your Continuing Competence Program (CCP) Learning Plan for 2022 and 2023.
Your employer(s)/organization(s)’s contact info. Your payment method, if not enrolled on the Pre-Authorized Payment Plan.
FEES, DEADLINES AND PROOFS
Fees may be paid online by credit card (Visa or MasterCard), or through previous enrollment in our Pre-Authorized Payment Plan (PAP). For different payment methods, contact the CLPNA during business hours to make alternate arrangements. All fees will change at 12:00 am (midnight) on the dates listed. In accordance with CLPNA Payment Policy, registration fees are in Canadian dollars and are non-refundable.
Reinstating Registration after Dec 31
On January 1, 2023, the Registration Renewal system will close and those who have not renewed will have their practice permit suspended. Those still wishing to register must complete the ‘Previously Licensed in Alberta’ process. Total fees will be $780 ($100 Application, $350 Practice Permit, $300 Registration Levy, $30 Criminal Record Check). If the applicant worked without a valid practice permit, a $500 Complaints fee is added, for a total of $1280.
Practice Permits
After Registration Renewal is approved, most LPNs will receive access to their Practice Permit and tax receipt. For those on the Pre-Authorized Payment Plan, access to their Practice Permit will become available after the final payment is processed in late November.
Proof of Registration on Public Registry
Proof of an LPN’s current and future registration status, practice conditions, and more can be found using the CLPNA’s Public Registry of LPNs at www.clpna.com
Prepaying Registration Renewal Fees for 2024
The new Pre-Authorized Debit plan (PAD) allows members to pay their 2024 Registration Renewal Fee using automatic bank withdrawals of $32/month for 10 months. After January 1, 2023, you may sign up for the PAD program. Login to myclpna.com to complete the online form.
Questions?
Contact CLPNA at registration@clpna.com, 780-484-8886, or toll-free at 1-800-661-5877 (toll-free in Alberta only).
care | FALL/WINTER 2022 7
RENEWAL FOR ACTIVE PRACTICE PERMIT Fees Paid October 1 - December 1 $350 Fees Paid December 2 - 31 $550 After December 31 Reinstatement Required $300 Registration Levy may apply as well as other applicable fees
2023 REGISTRATION
2 3 4 5
1
>
REGISTRATION RENEWAL 2023
ASSOCIATE MEMBERS FOR 2023
In response to recent changes in legislation, the College of Licensed Practical Nurses of Alberta has completed a review of its membership types. Associate (nonpracticing) membership was evaluated as part of this review, and it has been determined that the CLPNA will no longer be offering this membership as of January 1, 2023.
Associate Members of the CLPNA have been notified that their membership will expire on December 31, 2022 and will automatically be cancelled.
Those planning on returning to practice are encouraged to review the Requirements for Reinstatement
Applicants can apply for reinstatement at anytime. It is recommended that you apply a minimum of 4 to 6 weeks prior to returning to practice as an LPN. Those planning on reinstating in the future are encouraged to keep apprised of any policy changes.
CHANGES COMING TO LPN REGISTRATION DATES IN 2024
The CLPNA’s Council recently approved a change to the registration year. Starting in 2024, practice permits will be valid from December 1 - November 30, moving back the registration renewal period by one month to begin on September 1. This change will address the feedback from registrants and employers over the years that the current registration renewal period (ending December 31) is challenging during the holiday season.
WHAT DOES THIS MEAN FOR REGISTRATION RENEWAL?
Nothing will change in 2023. The renewal period for the 2024 practice permit will remain October 1 - December 31, 2023.
Registration fees will remain the same; however, they will be adjusted for the 2024 registration year only to reflect the temporary 11-month transition period.
Beginning in 2024, the annual registration renewal period for the 2025 practice permit will be September 1 - November 30.
LPNS PARTICIPATING IN THE PAD PROGRAM IN 2023
Those participating in the Pre-Authorized Debit Plan (PAD) will see a change in their payments for 2023 only. As those who take part in the program will be paying for their 2024 fees in advance, the monthly fee will be adjusted for an 11-month registration year. In 2024, it will go back to the 12-month registration fee when pre-paying for the 2025 practice permit year.
Practice Permit Year
2023 2024 2025
Registration Dates
January 1, 2023December 31, 2023
January 1, 2024November 30, 2024
December 1, 2024November 30, 2025
Registration Fee $350 $320 $350
Pre-Authorized Debit Cycle
February 1, 2022November 1, 2022
February 1, 2023November 1, 2023
January 1, 2024October 1, 2024
PreAuthorized Debit Fee
$35/month $32/month $35/month
QUESTIONS?
Contact CLPNA at registration@clpna.com, 780-484-8886, or toll-free at 1-800-661-5877 (toll-free in Alberta only).
8 care | VOLUME 36 ISSUE 2
STUDY with CLPNA
Professional development is an important part of maintaining nursing competence. The CLPNA provides several different online learning opportunities for LPNs. LPNs can access live or recorded webinars / videos, self-study courses, and registrant-only learning modules. Learning modules can be accessed by LPNs at myCLPNA.com


Find all study opportunities online at studywithCLPNA.com.
Continuing Competence Program (CCP)
MANDATORY EDUCATION: UNDERSTANDING RESTRICTED ACTIVITIES


Restricted activities are high-risk health services that have education, skill, and, at times, supervision requirements. The ‘Understanding Restricted Activities’ learning module helps LPNs understand restricted activities and how to assess if they are competent to perform restricted activities. It is mandatory for LPNs to complete the ‘Understanding Restricted Activities’ learning module prior to 2023 registration renewal being approved.
This requirement is a part of 2022 Continuing Competence Program activities and only needs to be completed once. To confirm that it has been successfully completed, please log in to your myCLPNA account and review your dashboard.
NEW LEARNING MODULES
Developing knowledge, unpacking preconceived notions, and dispelling ageism are important parts of nursing practice when working with older people. The CLPNA has partnered with the University of Alberta Faculty of Nursing to deliver three new learning modules designed to equip nurses with knowledge and skills to work with older people in a variety of settings. The clinical and research-focused content for these modules was developed by Dr. Sherry Dahlke, PhD, RN, GNC(C), Dr. Kathleen Hunter, PhD, RN, NP, GNC(C) and Dr. Maya Kalogirou, PhD, RN.
The learning modules are developed based on research outlining practicing nurses’ and student nurses’ learning needs related to working with older people. The modules will be available to LPNs through their myCLPNA login in early October 2022.
Cognitive Impairment - In a recent study, practicing nurses indicated their top learning need related to working with older people was understanding cognitive impairment and how to manage associated responsive behaviours.




Continence and Mobility - Research shows practicing nurses and student nurses indicated they need further professional development associated with the care of clients with continence and mobility issues. Integrative review of the literature revealed that nurses often lack the knowledge to assess continence needs and the mobilization of older people.
Understanding and Communicating with Older People - In a recent study, practicing nurses indicated they have a significant learning need related to communication with older people and managing older people with dementia, particularly when they are exhibiting responsive behaviours.

care | FALL/WINTER 2022 9
>
Webinars
Falls and Fall Prevention - Falls can change everything: Your role in prevention (Nov 8)
A fall can have a significant impact on a person’s independence and lifestyle. Among older adults in Alberta, falls are the leading cause of injury and 1 of 3 older adults will fall at least once per year. Join Melanie Morgan-Redshaw from the Injury Prevention Centre to learn about risk factors that can lead to a fall including issues with balance and leg strength, vision, medication, cognitive issues and home safety. Interventions which may help to prevent a fall, such as everyday movement, footwear and foot care and having a trip-free home, will be discussed. The Finding Balance falls prevention resources, including videos, information sheets and booklets, will be highlighted.
Learning objectives include:
• Recognize risk factors that can lead to a fall
• Identify interventions that may help prevent falls
• Become familiar with falls prevention resources that can be shared with older adults and family members.
Participate in a live Q&A with the University of Alberta Injury Prevention Centre and CLPNA representatives.
Visit the CLPNA Webinar webpage for more information and to register.
Falls Prevention/Vision Education for LPNs - Eye Health
Through the Ages. What you should know (Nov 22)
Regardless of age, eye health and vision problems can impact quality of life. Learn what to watch for as you support patients and how early identification can reduce the risk impact and increase quality patient outcomes. Join Dr. Salma Kiani, OD, as she walks you through what you need to know about eye health at every stage of life, how to refer and find an optometrist close to you, and how simple day-to-day steps can contribute to lifelong eye health.
Learning objectives include:
• What optometrists are trained and regulated to do
• What services are insured
• Why people should have eye exams at every stage of life
• Eye disease and the importance of co-management (diabetic retinopathy, cataracts, macular degeneration, glaucoma)
• Red eye can be much more than a simple eye infection
• Floaters and flashers and why these should never be ignored
• Concussion management
• Dry eyes and the impacts of leaving untreated
• Supporting eye health with diet, exercise, and UV light protection
Participate in a live Q&A with the University of Alberta Injury Prevention Centre, Dr. Salma Kiani, and CLPNA representatives.
Visit the CLPNA Webinar webpage for more information and to register.
Connecting Regulation to LPN Professional Practice (Nov 15 & 17)
The purpose of regulation is to ensure that regulated healthcare providers, such as Licensed Practical Nurses , practice in a safe, competent, and ethical manner.
The way LPNs connect their regulatory responsibilities to their nursing practice is of utmost importance. Professionalism requires that LPNs demonstrate professional standards when providing nursing care and collaborating with patients, colleagues, and other members of the healthcare team.
Join this webinar to understand how LPN professional practice in Alberta fits into the CLPNA’s regulatory responsibilities framework which includes legislation, regulation, the regulatory college, the employer, the LPN, and the public. All these components work together to protect the public.
Participate in a live Q&A with CLPNA representatives. Visit the CLPNA Webinar webpage for more information and to register.
Understanding Restricted Activities & Advanced Practice for LPNs (Dec 13 & 15)
LPN practice has evolved since 2003 when the regulation was first proclaimed under the Health Professions Act. The current regulation authorizes LPNs to perform a broader range of activities to support care provided to individuals and their families.
The LPN Profession Regulation identifies the LPN scope of practice related to restricted activities and advanced authorizations, including areas of advanced practice.
This webinar presentation will provide an overview of the Standards of Practice on Restricted Activities and Advanced Practice with specific focus on the following areas:
• Policy
• Restricted activities
• Advanced authorizations
• Advanced practice
• Education requirements
Participate in a live Q&A with CLPNA representatives. Visit the CLPNA Webinar webpage for more information and to register.
10 care | VOLUME 36 ISSUE 2
Motivational Interviewing



Walking With Grief
Others Deal With Loss
Trauma-Informed Care


care | FALL/WINTER 2022 11
this
the
21
rate: $249 Regular rate:
Check out the 1-hour Webinar version on December 21 1-HOUR WEBINAR Dec 12 1-HOUR WEBINAR Oct 28 To register or find more workshops, visit our website ctrinstitute.com Live Virtual Workshops
Based on our book, A Little Book About Trauma-Informed Workplaces,
workshop explores five key principles to integrate a trauma-informed approach throughout
organization. Nov
Early
$279�
VIRTUAL VIRTUAL Nov 15-16 EDMONTON Nov 15-16 Early rate: $459; Regular rate: $499 VIRTUAL Nov
Early rate: $249; Regular rate: $279 This
will
GET 10% OFF by using the coupon code ABN10 Specialize your skills and expand your career opportunities Discover our Critical Care and Emergency Nursing programs. Ideal for LPNs, RPNs, RNs and graduate nurses, these programs are entirely online and asynchronous so you can learn at your own pace. Visit MacEwan.ca/CriticalCare to learn more.
Helping
Strategies for Supporting Change This workshop is designed to give helpers an increased awareness of the dynamics of grief, and to provide tools and strategies to best support someone who is grieving.
1
workshop
provide new ways to facilitate the change process in the people they work with.
Understanding HCA Regulation
In Alberta, Health Care Aides (HCAs) are frontline healthcare workers. HCAs play a major role in providing Albertans with quality, person-centred care. HCAs work collaboratively as part of a healthcare team, under the supervision of a regulated healthcare professional. HCAs provide personal care and other essential health services in hospitals, continuing care facilities, group homes, and other healthcare settings.
In Alberta, most health professionals are regulated by regulatory bodies called “colleges” under a law known as the Health Professions Act (HPA). Regulated health professions include many different professions, from physicians and dentists to medical laboratory technologists and respiratory therapists. Currently, there are approximately 30 different regulated health professions in Alberta. Most regulatory colleges regulate a single profession, but some colleges regulate multiple professions.
In 2020, the HPA was amended to allow for regulation of HCAs as their own health profession; however, these amendments have not yet been implemented. When these amendments are implemented, HCAs will become one of those approximately 30 health professions regulated under the HPA. The College of Licensed Practical Nurses of Alberta will be the regulatory college for these two

distinct professions: Licensed Practical Nurses and Health Care Aides in Alberta.
Every profession regulated under the HPA has its own standards of practice and code of ethics. Although HCAs will be regulated by the CLPNA, HCAs and LPNs will be distinct professions, each with its own standards of practice and code of ethics. Alberta will be the first province in Canada to regulate HCAs as health professionals.
HCA Forums
As part of the CLPNA’s work to engage various stakeholders, including LPNs, HCAs, employers, educators, unions, and government, the CLPNA hosted virtual forums to start a conversation on HCA regulation in Alberta. The forums were held online to allow


12 care | VOLUME 36 ISSUE 2
iStock.com/Atstock Productions iStock.com/Atstock Productions
participants to attend from across the province. This was an opportunity for those who attended to provide feedback and ask questions directly to the CLPNA. The forum included a brief introduction, overview on HCA regulation, and breakout sessions to allow for smaller groups to explore key questions regarding HCA regulation in Alberta.
The following are a few of the frequently asked questions and answers from these forums.
What will change when HCAs become a regulated profession?
HCAs will become a profession and be accountable to their own standards of practice as with all other health professionals in Alberta.
The Health Professions Act establishes some common rules for all health professionals as well as authorizing a regulatory body, also known as a “college,” to create and enforce rules specific to each health profession. The job of a college is to protect the public from unsafe practice and hold registrants of the profession accountable for the care they provide to patients. Colleges also create additional policy documents to guide the application of these rules.
HCAs will have requirements for registration, continuing competence, and a mechanism for managing unprofessional conduct.
When HCAs become regulated, CLPNA will change its name to reflect that it regulates both LPNs and HCAs.
Will the scope of practice change for HCAs?
When Health Care Aides become a regulated profession in Alberta, their practice statement will be defined in Schedule 10 of the Health Professions Act
Standards of practice and a Code of ethics will further define the scope of practice for HCAs.
These documents, along with the Competency Profile for HCAs, will outline the knowledge, skills, behaviours, and attitudes required by all HCAs in Alberta and will further assist in clarifying the role and accountabilities of an HCA. When HCAs become regulated, their scope of practice will remain unchanged, meaning their day-to-day practice will not change.
What is the difference between education standards and continuing competencies?
There are standards for the education of HCAs, and postsecondary education programs are required to meet those standards in teaching the HCA program in Alberta. After students complete the HCA program and become registered
as HCAs in Alberta, they will be required to meet continuing competence standards or standards for practice. A continuing competence program provides a framework to ensure that registrants are continually learning to enhance their skills.
Will HCAs have a continuing competence program?
As required by the HPA, CLPNA must implement a continuing competence program for HCAs within 18 months of regulation. The continuing competence program will be specific to the needs of HCAs but will be administratively similar to the continuing competence program for LPNs.
The CLPNA is also required to perform an audit of registrants’ continuing competence learning. The process will involve a review of the learning that a registrant has undertaken. Audits will only commence after the continuing competence program has been fully established and operating for at least one year.
Is there going to be a timeline of when HCAs will be regulated?
While standards of practice will be adopted by the Council of the CLPNA, there are further regulations governing the practice of HCAs that will be developed in collaboration with the Alberta Ministry of Health and other relevant stakeholders. The exact date of when this regulation will be implemented by the Government of Alberta is unknown at this time.
The CLPNA will provide a timeline as soon as the regulation has a specific date. Until the regulation is implemented, the CLPNA is preparing by providing frequent communications.
Will there be more opportunities for LPNs to be involved?
The spring forums and survey were part of the CLPNA’s work to engage stakeholders for feedback and discussions around the upcoming HCA regulation. The CLPNA will be involving LPNs, HCAs, and stakeholders as opportunities arise.
How do I find more HCA regulation updates?
The CLPNA developed a dedicated website to provide updates on HCA regulation. Visit hcaregulation.com for updates and frequently asked questions. The CLPNA will also be providing updates through CARE magazine, our weekly newsletter, and direct emails to registrants. If you have any specific questions, please contact HCA regulation at info@hcaregulation.com. n
care | FALL/WINTER 2022 13
Working Towards a More Diverse, Equitable, and Inclusive Culture

Awareness of diversity, equity, and inclusion (DEI) is becoming more prominent in our world today. The pandemic, truth and reconciliation for Indigenous Peoples, and other prominent social concerns are emphasizing the importance of this concept. It is important to recognize that diversity, equity, and inclusion are much more than buzz words. They require a commitment to meaningful and measurable change demonstrated through continued action.
DEI is a complex and intentional endeavour that occurs at all levels within an organization and is everyone’s responsibility. The College of Licensed Practical Nurses of Alberta recognizes and acknowledges the importance of bringing a stronger focus to improving DEI practices in order to create meaning within the organization that aligns with our regulatory functions. When DEI shifts from being more than words and is put into action, organizations can create a culture of respect, acceptance, and engagement.
DEI has been identified as a core value and priority at the CLPNA, with the goal of embracing social and professional diversity as the organization carries out its regulatory functions. Nearly two years ago, the CLPNA committed to raise awareness of DEI by forming an internal DEI committee. The intention of the DEI committee is to help CLPNA employees focus on DEI practices that influence how the CLPNA approaches its work, makes decisions, and interacts with stakeholders, registrants, and the
14 care | VOLUME 36 ISSUE 2
public. This priority on DEI relates to the CLPNA’s strategic pillar of strengthening service delivery, as mentioned in the CLPNA’s 2022-2025 Strategic Plan.
The committee was formed by volunteers from several CLPNA departments with the purpose of developing organizational principles related to DEI. As each member of the committee came to the table with different lenses and perspectives, the inherent challenges of this type of work were highlighted.
The committee learned that patience, openness, and vulnerability are essential for encouraging productive conversations and learning.
A guiding concept was developed to help mitigate feelings of discomfort that often present when having meaningful conversations around DEI. At each meeting, the committee is reminded of the acronym, BASE: Belonging – Awareness – Safe – Embrace.

care | FALL/WINTER 2022 15 >
iStock.com/sakkmesterke
Once the work began, the committee agreed on the value of collaborating with DEI experts for support. Given that DEI is a large and complex concept and is continually evolving, the committee found that external guidance was helpful in forming a plan of action. Part of this plan was facilitating organizationwide education and training sessions on DEI for all staff and CLPNA Council members.
These sessions explored psychological safety, unconscious bias, and micro aggressions as key areas
of focus. Taking these concepts into consideration, the committee worked with the Performance Measurement and Research Team at CLPNA to come up with DEI principles for the organization and its employees. These principles are intended to guide how the organization will integrate DEI into CLPNA’s work, including policies, processes, and practices. Additionally, they represent how employees at the CLPNA approach one another and others.
CLPNA DEI Principles






Shared Commitment to One Another
We share the responsibility of creating a workplace focused on belonging, connection, learning, and compassion that includes everyone every day. We commit to approaching one another with patience and empathy, and recognize that as we continue to evolve, there are opportunities to change and do better.
Open & Safe Discussions
We nurture a safe space to share and express who we are. We value, respect, and recognize each other’s perspectives, unique abilities, needs, and experiences, and welcome diverse ideas and opinions. We are open and respectful in our discussions with a commitment to listen and learn from each other.
Unwavering Commitment
We stand against any form of racism, discrimination, and inequity. Our words, actions and behaviours affect others, and we commit to acting when we encounter intolerant remarks and behaviour.
Call to Action
We acknowledge the past harms inflicted on Indigenous Peoples and commit to learning from history. We seek to understand our role in working towards truth and reconciliation and to determine our actions for change.
Learning Mindset
Everyone is encouraged to seek opportunities to continually explore, reflect, learn, and grow to be more open and aware of diversity, equity, and inclusion. We commit to learning and engaging in conversations about different views and perspectives, and the impact of biases in our workplace and society.
Intention in Our Work
We deliberately apply a diversity, equity, and inclusion lens to our actions, behaviours, practices, and policies. We commit to taking actions to address instances when our principles are not being honoured.
16 care | VOLUME 36 ISSUE 2
Creating a culture of diversity, equity, and inclusion is an ongoing, fluid, and thought-provoking process. The CLPNA believes that when done with intention, organizations can create a culture of respect, acceptance, and engagement.
In alignment with guiding CLPNA registrants to provide culturally competent and inclusive practice, we too, as leaders, staff, committee members, and Council are embracing the opportunity to learn and take action toward our goal of becoming a more interculturally competent organization. The CLPNA is committed to modelling sustainable actions for
PODCASTS
1. CLEAR podcast: Understanding Unconscious Bias
continued growth and learning towards cultural competence and safety in the Alberta healthcare system.
The following is a list of resources that supported the CLPNA DEI committee in the development of the guiding principles. n
CLEAR podcast: Recognizing Unconscious Bias and Minimizing its Impact
Brené Brown with Aiko Bethea on Inclusivity at Work: The Heart of Hard Conversations
Brené Brown with Aiko Bethea on Creating Transformative Cultures
Brené Brown with Dr. Yaba Blay on One Drop: Shifting the Lens on Race
The Hon. Murray Sinclair on why we need truth for reconciliation
ARTICLES/BLOGS
1. Article: What Inclusive Leaders Sound Like
Article: Stronger Together: A Credentialing Organization’s Story of Promoting Diversity, Equity and Inclusion
Article: Hospital orderly, caught on video mocking Joyce Echaquan before she died, tells inquest she meant no harm
Blog Article: Why do nonprofits struggle with diversity?
Connecting Spirituality With the Land and Each Other
Understanding Treaties is Essential to Understanding
When is it OK to wear an item from another culture, and when is it appropriation? How to tell
VIDEOS/WEBINARS
Start with why – how great leaders inspire action | Simon Sinek
Setting the Foundation for Good Relations in Our Homeland
Land Acknowledgement
The Disability Conversation | Ben Myers | TEDxOStateU
Treaty Talk: Sharing the River of Life
Treaty Talk: A Journey for Common Ground
WEBSITES
1. Canadian Virtual Hospice’s LivingMyCulture.ca
Centre for Race and Culture
care | FALL/WINTER 2022 17
2.
3.
4.
5.
6.
5.
7.
2.
3.
4.
Turtle Island 6. Joyce’s Principle
8.
9.
1.
2.
3.
4.
5.
6.
2.
Caring Without Judgment: Harm Reduction
 Co-authored by AHS Harm Reduction Services and CLPNA staff
Co-authored by AHS Harm Reduction Services and CLPNA staff
18 care | VOLUME 36 ISSUE 2
Helmets for hockey. Oven mitts in the kitchen. Stopping before that fourth cup of coffee. All of these are ways we reduce harm every day. Licensed Practical Nurses are also learning the importance of reducing harm, through the policies and practices known as harm reduction.
Harm reduction is an umbrella term that covers a wide range of health, social, and economic approaches. It is often thought of as risk mitigation, risk management or safety planning and is something healthcare providers do instinctively every day. It can look like education, skill and capacity-building, providing support or resources, referrals, and relationship building.
In the recent webinar co-hosted by the College of Licensed Practical Nurses of Alberta (CLPNA) and the Alberta Health Services (AHS) Harm Reduction Services Team, Sara Gill, RN, BSN, and Tahira Merali, RN, MPH, BN, BSc, provided information on harm reduction, an overview of this public health approach in programs and practice, and practical strategies in caring for people who use substances.
This article builds on that webinar to further discuss harm reduction and provide additional strategies for your practice. >

care | FALL/WINTER 2022 19 Cover Story
Harm Reduction
Harm reduction supports public health by aiming to minimize the harmful consequences of substance use through policies, programs and practices that focus on wellness for the individual, wherever they may be on the spectrum of substance use. It is important to understand how someone views their substance use on this spectrum, so that you can foster conversations around supporting their goals and the plan for care.
Beneficial Use
Use that has positive health, social, or spiritual effects (such as using medication as prescribed, or ceremonial tobacco).
High-Risk / Harmful Use
Use that begins to have negative consequences for a person, friends, family, or society (such as combining multiple substances or driving under the influence).
Use that has negligible health or social effects.
Casual / Low-Risk Use
High-risk use that becomes habitual and compulsive despite negative effects.
Chronic Dependence / Substance Use Disorder
The spectrum is not a diagnostic tool for healthcare providers to determine whether substance use is problematic. It is a tool for the person seeking care to communicate how they view their substance use. Note that an individual’s journey may involve them jumping between points along the spectrum.
Guiding Principles of Harm Reduction
People use substances for a variety of reasons. Whether the use appears beneficial or harmful to an outside observer, it is important to remember it has a purpose for the person using. Using substances includes everything from caffeine and prescribed medication to substances that are illegal.
Harm reduction is founded on kindness, compassion, and caring, and is underpinned by several key principles. These principles are consistent with the concept of social justice and the healthcare professionals’ foundational responsibilities, values, code of ethics, code of conduct, and standards of practice.
Pragmatism: recognize substance use as a universal phenomenon that provides personal benefits; use is viewed as being on a spectrum from beneficial to harmful; and not everyone who uses substances has an addiction or dependence
Human rights: respect the basic human dignity and rights of all individuals who use substances
Focus on risks and harms: a person’s substance use is secondary to the harms that can occur from the substance use itself
20 care | VOLUME 36 ISSUE 2
Maximize intervention options: recognize that people have unique needs and that the most beneficial approach is to use a variety of different interventions
Priority of immediate goals: envision a hierarchy of achievable steps toward a goal that can be taken one at a time, prioritizing needs as determined by the person using substances
Incrementalism: recognize that small steps towards a goal are as important, if not more important, than the end goal itself
Involvement of people with lived experience: from policy and program planning to service delivery, involving people with lived experience in substance use, or loved ones impacted by substance use, is essential so that their needs and preferences are represented in the outcome
Evidence based: harm reduction is a public health approach based on evidence and years of research
Social justice and accessibility: in addition to the clinical focus, harm reduction is first and foremost a movement towards social justice
*These guiding principles are collected from various harm reduction organizations, training manuals, and research literature.
Harm reduction includes interventions that can be targeted towards the patient, family, community, or society. This approach is an important element in a continuum of care, meaning the delivery of services across sectors by different healthcare providers. It is a life-saving measure that should be available to anyone who uses substances. A harm reduction approach applies not only to harm due to substance use, but also social harms that impact health and well-being.
The benefits of harm reduction can be viewed at the individual, community, and societal levels and include:
• Health benefits - improved physical and mental health
• Social benefits - improved order and inclusion in society
• Economic benefits - decreased costs to the healthcare and justice systems
Benefits for the individual include:
• Prevention of infections including HIV and hepatitis C through decreased sharing of equipment
• Decreased emergency department visits and deaths
• Connection and referrals to health and social services and treatment programs
• Empowerment and capacity building, and restored dignity and self-esteem
care | FALL/WINTER 2022 21
Harm reduction is meeting people where they are at and providing options appropriate to them
HUMAN
FOCUS ON RISKS AND HARMS MAXIMIZE INTERVENTION OPTIONS PRIORITY OF IMMEDIATE GOALS INCREMENTALISM INVOLVEMENT
PEOPLE
- Alberta Health Services LIVED EXPERIENCE
” EVIDENCE BASED
PRAGMATISM SOCIAL JUSTICE AND ACCESSIBILITY
RIGHTS GUIDING PRINCIPLES OF HARM REDUCTION >
OF
WITH
Harm Reduction is a Mindset
Harm reduction is a mindset that incorporates being trauma-informed and person-centred. It means letting the person take the lead and not being attached to predetermined outcomes. Harm reduction is meeting people where they are at and is easy to incorporate into practice; it’s not just programs or supplies, but how you approach people.
Healthcare providers have an ethical obligation to respect the decisions made by an individual, even if those decisions may cause harm. Attempting to prevent certain behaviours can take away the person’s autonomy and ability to cope with their experiences. It can increase the person’s distress by failing to recognize the full picture of why a person continues to use substances.
Reflect On Your Personal Values
For some, harm reduction may be an uncomfortable idea. Giving out substance use supplies may feel counterintuitive or be viewed as endorsing substance use. Harm reduction aims to reduce the harm related to substance use by giving people options and tools to use in a safer way, including providing access to sterile supplies, education on safer practices, poisoning response training, connection to resources, and most importantly, by offering compassion.
Regardless of their personal values, beliefs and culture, healthcare providers are expected to interact with a person who uses substances without judgment or stigmatizing language and actions. Providers should have the understanding that everyone’s journey is influenced by a variety of social and structural factors. It is important not to judge. Take time to learn about your patient’s world, and their journey might become clearer. Keep in mind that everyone has the prerogative to make their own decisions and choose their own actions, and that should be respected.
As a healthcare provider, reflecting on your personal values and beliefs is key to harm reduction. Examine where your values and beliefs about substance use come from, and how culture and society may have influenced your perspective. Be kind to yourself and allow yourself to be open to learning new ways of
thinking. Healthcare providers have an ethical duty to understand the social and structural determinants of legal or illegal substance use in order to provide safe, ethical, and competent patient-centred care.
Ask yourself the question, how will you change your practice to better support your patients who use substances, and their families?
Reducing Stigma
For individuals who use substances, stigma has the power to perpetuate hopelessness, negative self-concept, and social isolation, and fuels the reluctance to access health services. Stigma can cause decreased quality of care, making people less willing to come back for future or ongoing treatments. In the end, patients may end up with more advanced illness due to their apprehension about seeking treatment.
Approaches To Reducing Stigma
• Be aware of your behaviours and unconscious biases
• Practice with compassion and acceptance
• Celebrate the small wins – focus on positive changes with your patient despite their challenges
• Provide quality care and accept harm reduction into your practice
• Educate yourself and understand the facts around harm reduction, mental health, and addiction
• Respect the basic human dignity and rights of all individuals regardless of life circumstances
22 care | VOLUME 36 ISSUE 2
- Alberta Health Services
Imagine how eliminating stigma could have significant health and social benefits for people who use substances. We as healthcare providers are challenged to recognize and address our own internalized stigma to benefit patient care.
Including Harm Reduction In Your Practice
The commitment to providing safe, ethical, and competent care includes understanding a harm reduction approach, and awareness of its impact on patient care. Nurses should be able to demonstrate the knowledge and ability to support patients, families, and others with coping strategies and community-based resources around harm reduction.
In practice, introducing a harm reduction approach supports ethical practice in healthcare. A harm reduction approach is:
• Non-stigmatizing and welcoming
• Kind, compassionate, and respectful of people using substances
• Low-barrier, flexible and accessible
• Person centred
• Focused on relationship and trust building
• Trauma-informed
• Conscious of cultural safety
• Concerned with reducing the harms associated with continued use of a substance and enhancing quality of life
• A part of promoting public health
The role of healthcare providers
Small things can make a big difference and help a person feel hopeful and supported.
• Listen
• Show compasion
• Be understanding
• Be kind
Quick Dos and Don’ts to be a Harm Reduction Champion DO...
o Build rapport first (prioritize the relationship)
o Remember that using substances does not mean someone has an addiction; substance use is on a spectrum
o Let the client lead in care planning (support them in their self-identified goals)
o Ask questions and be open to learning new things
o Celebrate all wins (even the small ones)
o Honour lived experience (they are experts in their own lives)
o Reduce structural barriers for all people who use substances
o Take care of yourself (have good work-life balance and support systems)
o Understand that people have the right to receive equitable, nonjudgmental, and evidence-based healthcare services regardless of whether the substances they use are legal or illegal
DON’T...
o Use stigmatizing language, such as addict, junkie, user, misuse, dirty/clean, relapse, drugseeking, frequent flyer (be aware of the words you use in conversation and in documentation as this can create a narrative about the patient for the rest of the care team)
o Make assumptions (people are unique and all substance use is individual – you never know what someone is going through and why they may act as they do)
o Have a predetermined outcome in mind (it’s their journey and goals can fluctuate or change)
o Let stigma interfere with a patient’s care; stigma impacts care, treatment, and recovery from a mental health condition or substance use disorder
care | FALL/WINTER 2022 23
People will continue to experience harm from substance use if stigma prevents them from seeking help
”
>
Resources for Healthcare Providers
• AHS Community Based Naloxone Program
• AHS Harm Reduction Services
• AHS Help in Tough Times: complete support resources page for Alberta
• Harm Reduction Nurses Association (HRNA)
• Alberta Nurses Coalition for Harm Reduction (ANCHR)

• Community AIDS Treatment Information Exchange (CATIE): general harm reduction page
• Alberta Alliance Who Educate and Advocate Responsibly (AAWEAR): provincial peer-led organization providing education and support to communities impacted by substance use
• DrugSafe.ca: AHS safer substance use and support resources for the public
• National Overdose Response Service (NORS): or 1-888-688-NORS (6677), a 24/7 helpline for virtual supervised consumption
• Grieving Together: AHS grief support resources
• Grief: Loss as a result of substance use: resources for grief and loss due to substance use
• Moms Stop the Harm: network for support, resources, and advocacy
Additional Training Resources
• AHS Alberta Addiction Education Sessions | Livestream
• AHS Alberta Opioid Dependency Treatment Virtual Training Program
• AHS Concurrent Disorders Learning Series
• AHS Developmental Pathways of Addiction and Mental Health
• AHS Provincial Addiction Curricula & Experiential Skills (PACES) Training
• AHS Trauma Informed Care e-Learning Modules
• AHS Addiction & Mental Health Information for Health Professionals n
Watch the CLPNA video Harm Reduction: Theory and Practice, presented by the AHS Harm Reduction Services team, to gain more of an understanding of harm reduction, services available in the community, and practical strategies to care for people who use substances.
This article refers to information provided by Alberta Health Services and material used in the CLPNA Harm Reduction video (2022). For full list of references, please contact communications@clpna.com.
24 care | VOLUME 36 ISSUE 2
Introducing Alberta Association of Nurses (AAN): the first professional association for all Alberta nurses. You Belong. Together, we will: • Facilitate professional development opportunities • Create opportunities for nurses to connect with nurses • Recognize and celebrate outstanding nurses and practices • Capitalize on our collective nursing voice to advocate for and improve the nursing practice in Alberta Usecode RSAHCMKH andget20% offyour membership Join today and help shape AAN www.albertanursing.ca | @alberta_nursing

care | FALL/WINTER 2022 25 Benefit from the power of your group As a registrant of the College of Licensed Practical Nurses of Alberta, you can save more on your home and auto insurance because your regulatory college has partnered with The Personal. Exclusive group rates Bundle and save discounts Advisors who help you find other ways to save The Personal refers to The Personal Insurance Company. The Personal® and related trademarks are trademarks of The Personal Insurance Company, used under licence. Certain conditions, limitations and exclusions may apply. Learn more about the advantages of being part of your group. thepersonal.com/clpna 1-888-476-8737 For every insurance quote completed by a College of Licensed Practical Nurses of Alberta member, The Personal donates $5 to the Fredrickson-McGregor Education Foundation to help support enhancing the continuing education needs of LPNs. 2200283_G0400_Camp1_AD-AH_7x9,625_REST_En.indd 1 2022-04-14 16:03
STIGMA WHY WORDS MATTER
ABOUT STIGMA
Stigma is negative attitudes, beliefs or behaviours about or towards a group of people because of their situation in life. It includes discrimination, prejudice, judgment and stereotypes, which can isolate people who use drugs.
Stigma matters
People who use drugs, especially those struggling with addiction face discrimination and barriers to getting help. Stigma can:
• lead a person to avoid getting help because they are afraid of judgement or getting in trouble with work, their loved ones or even the law
• cause a person to hide their drug use or use drugs alone
• affect a person’s ability to find housing and jobs, which affects their health and quality of life
• contribute to people who use drugs receiving a lower quality of care from the healthcare system when they access services
Changing how you talk about drug use
The language you use has a direct and deep impact on people around you. You can reduce stigma by changing the words you use to talk about drug use. Using kind words can make it easier for someone to speak up, to feel understood or to receive help.
• Use person-first language, for example say ‘person who uses drugs’ instead of ‘drug user’
• Use neutral, medically accurate words when describing drug use.
Topic Instead of Use
People who use drugs
• Addicts
• Junkies
• Users
• Drug/substance abusers
• Recreational drug users
People who have used drugs
Drug use
• Former drug addict
• Referring to a person as being ‘clean’
• Drug/substance abuse
• Drug/substance misuse
• Problematic drug/substance use
• People who use drugs/substances
• People with an addiction or substance use disorder
• People with lived/living experience
• People who occasionally use drugs
• People who have used drugs/substances
• People in recovery
• People with lived/living experience
• Drug/substance use
• Addiction/substance use disorder
• Drug dependence
• Higher-risk drug/substance use
• Substance use harms
26 care | VOLUME 36 ISSUE 2
There are three types of stigma
1 Self stigma happens when someone internalizes messages about people who use drugs and apply them to themselves
2 Social stigma is negative attitudes or behaviours towards people who use drugs or towards their friends and family
3 Structural stigma is policies in health and social services that increase stigma and barriers to getting help
Help end stigma
Take these important steps to help reduce stigma: do not define any person by their drug use be respectful, compassionate and caring to those who use drugs
educate your friends and family—pass on facts and challenge stereotypes
remember that addiction is a treatable medical condition, not a choice, and is deserving of care just like any other medical condition
be aware of your attitudes and behaviours because they may be influenced by stereotypes, negative stories and images about people who use drugs

care | FALL/WINTER 2022 27
This
was created in discussion with people with lived and living experience, through existing research and documentation from other organizations trying to address stigma. This is not an exhaustive list. As discussions evolve around the best language to accurately describe substance use, this list may be revised. © Her Majesty the Queen in Right of Canada, as represented by the Minister of Health, 2022 Cat.: H14-297/3-2022E-PDF ISBN: 978-0-660-44083-5 Pub.: 220221 For more information visit Canada.ca/opioids
document
STIGMA WHY WORDS MATTER

28 care | VOLUME 36 ISSUE 2 iStock.com/peterschreiber.media
Research Study:
The Relationship Between Work Environment and Nurse Health
Nurses comprise a significant portion of the healthcare workforce, playing a critical part in the safe delivery of patient care. It’s easy to see the importance of a nurse’s own well-being given their role in supporting the health of others. As regulated health professionals, Licensed Practical Nurses must assess their health and wellness in the context of their professional responsibilities to ensure their physical, mental, and psychological capacity to safely care for patients.
For many organizations, provider wellness is a priority. Some healthcare organizations have implemented initiatives to support the well-being of their workforce as a strategy for providing safe, high-quality healthcare. Many initiatives include training opportunities in mindfulness and resilience, focusing on the individual care provider. While supports at the individual level are certainly valuable, some studies indicate workplace wellness initiatives are more effective when they target both individual and environmental factors.1 This makes sense, given that in healthcare as well as many other sectors, work environment is known to influence workers’ well-being.
In simple terms, “work environment” refers to the conditions in which employees do their work. Nurse work environment, specifically, is commonly defined in the research literature as

care | FALL/WINTER 2022 29 >
“the organizational characteristics of a work setting that facilitate or constrain professional nursing practice.”2 When looking at work environments, researchers have been particularly interested in understanding what makes a healthy or positive work environment. A few key components of a positive work environment are consistently noted in the literature - these include responsive and accessible leaders, participative management styles, opportunities for staff to participate in committees and other organizational level activities, collaborative working relationships, and sufficient resources to provide quality care.3
In studies of nurse work environments, researchers often use the Practice Environment Scale of the Nursing Work Index (PES-NWI)4 to collect nurse perceptions on these different components of their workplace. A study conducted by Phillips, de Los Santos, Ntanda, and Jackson (2021) examined such perceptions of nurse work environment in a group of LPNs. The study is based on a 2018 survey sent to all LPNs actively registered in Alberta at that time.
The study examined the relationship between LPNs’ perceptions of their work environments and their healthrelated quality of life (HRQoL). HRQoL, defined as “a multidimensional concept that includes domains related to physical, mental, emotional, and social functioning,”5 was measured with the widely used 36-item Short Form Health Questionnaire (SF-36).6
The study aimed to answer: (a) how LPNs rate their physical and emotional health in general and (b) whether work environment has any influence on the health of LPNs.
Over 4,000 LPNs participated in the survey. The average age of participants was 39 years with over 90% self-identifying as female. When compared to a similar demographic group from the general Canadian population, participating LPNs reported lower health-related quality of life. Moreover, LPNs indicated experiencing more fatigue than
their general population counterparts. Interestingly, this group of LPNs reported higher health scores compared to the SF-36 scores of other groups of nurses from other studies found in the literature.7
Overall, work environment appeared to influence LPN health. In general, the more positively an LPN perceived their work environment, the better their self-reported health. Of particular note, all dimensions of physical health and emotional wellbeing appeared to be influenced by perceptions of the adequacy of staffing and resources. That is, when LPNs felt there were enough staffing and resources to support safe, high-quality care in their work setting, the better they felt physically and emotionally. It’s of additional note that the positive relationship between work environment and LPN health remained even after controlling for resilience – meaning the researchers ensured higher health scores could not be alternatively explained by higher levels of participant resilience.
For anyone seeking to understand LPN health, this last finding underscores the importance of considering the work environment. As previously mentioned, many organizational wellness initiatives focus on individual factors. Although factors such as an individual’s resiliency undoubtedly contribute to one’s sense of wellbeing, this study highlights that individual factors do not comprise the full picture. It’s also important to consider what’s happening in the workplace. It could be of particular benefit for organizations to look at staffing and resources given their link to LPN health as found in this study.
The study, titled The impact of the work environment on the health-related quality of life of Licensed Practical Nurses: A cross-sectional survey in four work environments, is published in the journal Health and Quality of Life Outcomes. The full article can be accessed here n
For more information or a list of references, please contact us at communications@clpna.com.
30 care | VOLUME 36 ISSUE 2
All dimensions of physical health and emotional well-being appeared to be influenced by perceptions of the adequacy of staffing and resources
”
CONCUSSIONS

care | FALL/WINTER 2022 31 GOVERNMENT OF CANADA SUPPORTING TOOLS AND INFORMATION-SHARING REST for 24-48 hours, followed by a gradual, medically supervised return to activity WHAT DO CANADIANS KNOW ABOUT CONCUSSIONS? Unintentional injuries are a leading cause of death, hospitalization, and disability among Canadians… and of these, concussions are among the most common CONCUSSIONS COMMON TYPE OF INJURY ARE A The Government of Canada has developed evidence-based information and practical tools for: PARENTS ATHLETES COACHES TEACHERS SCHOOL & SPORTS ADMINISTRATORS HEALTH PROFESSIONALS 45% Assaults/ self-harm Other unintentional causes 20,000 FEMALES Approximately MALES 54% Assaults/ self-harm Other unintentional causes Sports & recreation 26,000 Approximately Awareness or compliance among coaches, athletes and parents Education and training among providers Knowledge or training in diagnosis of concussion There is an ongoing need to integrate any new knowledge on concussion prevention and treatment among allied health professionals, coaches, athletes, parents, and education providers Canadian Guideline on Concussion in Sport A Return to School Strategy A Return to Sport Strategy Canadian Harmonized Concussion Protocols A SchoolFirst resource for teachers and school boards to support children and youth after experiencing a concussion Mobile App to guide parents in the management of their child’s concussion Public Health Agency of Canada Agence de la santé publique du Canada ISBN 978-0-660-25818-8 Many youth experience concussions during sports and recreation activities, sometimes with tragic outcomes Visit www.canada.ca to access concussion tools and information Canadians have little or no knowledge about concussion do not know how concussion is treated Only 15% can correctly identify the best ways to treat concussion
4 in 10 are aware of available concussion tools or resources
IN
Sport and Recreation-related Traumatic Brain Injuries among Canadian
and Youth
Only
CONCUSSION
SPORT
Children
Approximately
age*
National Ambulatory Care Reporting System
44%
from to 27% are the sports with the highest proportion of brain injuries among children and youth 5-19 years of age
in in
DIAGNOSED
in 2016-17 by hospital emergency departments for children and youth 5-19 years of
*
(NACRS)
ranging
ICE HOCKEY, RUGBY AND RINGETTE of all injuries that happened while playing these sports* * Canadian Hospitals Injury Reporting and Prevention Program (CHIRPP)
FOOT CARE: Every Nurse's Responsibility
Assessing a patient’s feet is part of a comprehensive head-to-toe assessment and is vital to ensuring optimal health outcomes for a patient. The assessment of a patient’s feet may indicate abnormalities or an underlying disease process such as those involving complications with the heart, liver or kidneys, deficits in self-care, nutritional disorders, systemic diseases, infectious processes and more (Gallagher, 2012).
In Alberta, nurses are able to provide different levels of foot care. All Licensed Practical Nurses obtain the foundational knowledge to provide basic foot care as part of their entry-level education. Advanced foot care requires an LPN to obtain further education and be authorized by the College of Licensed Practical Nurses of Alberta to perform it. Foot care is an essential part of nursing in many care settings. Therefore, it is important to understand the key differences between basic and advanced foot care to ensure that LPNs are practicing within their scope of practice.

32 care | VOLUME 36 ISSUE 2
iStock.com/Olesya Eroshenko
What are the differences between basic and advanced foot care?
• Assess and inspect the feet for: - common microorganisms, or - compromised circulation
• Perform non-invasive foot care procedures: - cleaning, - moisturizing, - simple dressings, and - toenail care (straight across trim and filing when the foot is healthy and currently does not have circulatory compromise)
• Determine when foot care extends beyond basic foot care
• Initiate referrals for advanced practice foot care when patient needs are beyond the scope of basic foot care
See “Competency Profile for LPNs, E-5” for more information
• Restricted activity authorization under the LPN Profession Regulation
• Provide invasive foot care treatments (including for those with compromised circulation): - removal of tissue, corns, or callus, - toenail care (beyond a straight across trim of the nails), and - operation of manual or electronic tools and devices
• Recognize, monitor, and manage abnormalities and disorders of the lower limb and foot
• Implement principles of wound management for advanced practice foot care
• Initiate further referrals when patient needs are beyond the scope of advanced practice foot care as needed
See “Competency Profile for LPNs, E-6” for more information
What are the educational requirements for LPNs to provide basic and advanced practice foot care?
•
•
*In this document, “registrant(s)” has the same meaning as “regulated member(s)” in the Health Professions Act
Understanding the difference between basic and advanced practice foot care provides a better understanding of how your practice can meet patient care needs. Assessment and care of the feet is an integral part of nursing care and every nurse’s responsibility. You may wish to consider advancing your nursing practice by completing additional education and obtaining authorization in advanced practice foot care. n
REFERENCES
Useful Links:
• Standards of Practice: Restricted Activities and Advanced Authorizations - College of Licensed Practical Nurses of Alberta
• Competency Profile: Competency Profile for LPNsCollege of Licensed Practical Nurses of Alberta
• Practice and Education Requirements: Practice & PolicyCollege of Licensed Practical Nurses of Alberta
• Advanced Authorization Courses: Restricted Activities and Advanced Authorizations - College of Licensed Practical Nurses of Alberta
Gallagher, Diana. (2012) The Certified Foot Care Nurse and the Importance of Comprehensive Foot Assessments, Journal of Wound, Ostomy and Continence Nursing. Volume 39 - Issue 2 - p 194-196 doi: 10.1097/WON.0b013e318249f8b9
care | FALL/WINTER 2022 33
Registrants* of the CLPNA that have successfully completed a CLPNA approved practical nursing program or equivalent
Registrants that have completed a CLPNA Council approved advanced practice foot care program and have been authorized by the Registrar to practice advanced foot care
Basic Foot Care
Advanced Practice Foot Care
Basic Foot Care
Advanced Practice Foot Care

34 care | VOLUME 36 ISSUE 2
25TH ANNUAL Professional Conference November 9-12, 2022 | Calgary, AB & Online • LEARN about significant advancements in diabetes research, treatment and care. • RECEIVE exclusive access to more than 40 dynamic sessions (including recordings). • TAKE PART in engaging exchanges with peers and industry experts via structured networking activities. Selected sessions will be broadcast live. WANT TO LEARN ABOUT NEW MEDICAL ADVANCEMENTS IN DIABETES TREATMENT AND CARE? ADVANCE PRICING ENDS NOVEMBER 4! REGISTER TODAY TO END DIABETES dcanconference.ca
2022 PROFESSIONAL CONFERENCE TOGETHER IN CARE
Knowing the difference between basic and advanced practice foot care can provide a better understanding of how LPN practice can meet patient care needs. Assessment and care of the feet is an integral part of nursing care and is every nurse’s responsibility. LPNs may wish to consider advancing their nursing practice by completing additional education and obtaining authorization in advanced practice foot care. For more information, email the CLPNA’s Professional Practice Team or call 1-800-661-5877 (toll-free in Alberta), or 780-484-8886.
Are your patients at risk for diabetes-related foot complications?
Remember to… Look, Feel and Ask.
1. SKIN: Is the skin dry or callused? Are there open areas such as blisters or ulcers?
2. NAILS: Are nails well kept or unkempt?
3. DEFORMITY: Have there been changes to the bony structure of the foot? They may be indicative of Charcot .
4. FOOTWEAR: Does the patient’s footwear fit properly? Are the shoes appropriate for the activity for which they are being used?
5. TEMPERATURE: Is the foot cool? This may be indicative of arterial disease.
Is the foot hot? This may be indicative of inflammation, infection or Charcot .
6. RANGE OF MOTION: Check the hallux range.
7. SENSATION: Use a monofilament to test 10 sites on foot to potential neuropathy.
8. SENSATION: Ask 4 questions to detect potential neuropathy:
For Best Practice for the Prevention Diabetic Foot
www.woundscanada.ca/BPR_DFU
For more information cardiovascular please visit: about-diabetes
To purchase Wounds Canada www.woundscanada.ca/eboutique
For patient covered to the www.woundscanada.ca/healthyfeet
Frequency of assessment is dependent on findings. *Based on Inlow 60-Second Foot Screen
9. PEDAL PULSES: Are pulses present, absent or bounding?
10. DEPENDENT RUBOR: This may be indicative of poor arterial flow or perfusion.
11. ERYTHEMA: This may be indicative of inflammation, infection or Charcot changes.
P.O. Email: Website:
diabetes.ca | 1-800
Production through a financial Health Agency herein do not the Public
This brochure and should
care | FALL/WINTER 2022 35
©
Association
Canadian
Reproduced with permission from Diabetes Canada.


36 care | VOLUME 36 ISSUE 2 Daily Mouth Care: • Moisturize lips • Do visual mouth & denture check • Remove & brush dentures AM & PM • Clean mouth tissues and tongue • Soak dentures in disinfectant daily • Take dentures out at night or 4-6 hours/day • Gloves, towel, cup & water • Water-based lip lubricant • 4x4 gauze or face cloth • Soft toothbrush • Denture brush (2 headed) & denture cup • Liquid soap for dentures or denture paste • Commercial disinfecting denture cleaner • Other options: tongue cleaner, clasp brush for partials Label all supplies & dentures with resident’s full name
adhesives: use zinc-free products; use maximum
pea-sized dollops/denture; powdered adhesives are preferred.
tablets: have
allergic/ toxic reaction. For safety, store tablets out
reach! You will need: BASIC MOUTH CARE Caring for Those With • Dentures • False Teeth • No Teeth
Denture
3
Denture
caused
of resident’s
Step-by-Step Denture Care
• Individualize mouth care. Consider the resident’s medical (e.g., dementia), oral (e.g., dry mouth), positioning (e.g., dysphagia), and mobility (e.g., in wheelchair) issues.
• Wear new gloves. Wear a mask and protective eyewear if risk of splatter. Place towel under chin.
• Lubricate lips before and after for comfort and to prevent cracking. Note: petroleum-based products increase the risk of aspiration pneumonia and weaken gloves.

• Line the sink with a towel to prevent breakage of the denture if dropped.
• Remove complete denture. Ask resident to remove, or use a rocking motion to break the seal. Tip: ask resident to blow with lips closed to help break suction. Remove partial denture. Place thumbnails under clasps and carefully lift out so as not to bend the clasps or injure tissues.
• Rinse with cool water to remove debris. Hot water can warp dentures.
• Thoroughly brush all surfaces using liquid hand or dish soap (not toothpaste) and a denture brush; rinse well after. Remove adhesives daily to prevent infection. Note: use the small brush to clean the tissue side of the denture. Clean metal clasps gently with soft toothbrush or by twirling clasp brush.
• Disinfect dentures daily by soaking in a commercial denture cleaner/tablet (following manufacturer’s instructions). After disinfecting, rinse thoroughly under running water for one minute before replacing. When placing dentures in mouth, tissues should be wet for retention; replace the upper denture before the lower one. If safety is an issue, although not ideal, dentures may be soaked in cool water or air dried over night following thorough cleaning. Note that water does not reduce bacteria and if air drying, any remaining debris will become hard and difficult to remove.
Mouth Tissue Care
• Retract lips & cheeks with gloved fingers or toothbrush; never place fingers between teeth.
• Clean and massage all mouth tissues—cheeks, gums, roof & floor of mouth—using gauze, face cloth or soft toothbrush.
• Clean tongue with soft toothbrush from the back to the tip using large, sweeping strokes. Bacteria on the tongue is the major cause of BAD BREATH. Consider a tongue cleaner.
• Rinse brushes with warm water, tap to remove excess water, and stand up to dry. Don’t store used brushes in a closed space or container as they will grow bacteria. Clean and air dry denture cup daily.
• Replace brushes when bristles are worn and splayed or if resident is ill (virus, herpes, candidiasis/ thrush, etc.). Immuno-compromised individuals should have their brushes replaced more frequently (cancer care, HIV, transplant, dialysis, etc.)
Note:
• For a poorly fitting denture or one with heavy deposits, make a dental referral.
• Dry mouth will make denture retention more difficult. Try a mouth moisturizer.
care | FALL/WINTER 2022 37
(Credits © M Bertone, ME Wener, CP Yakiwchuk. Revised 2018)

38 care | VOLUME 36 ISSUE 2 End of shift @CLPNA iStock.com/Missing35mm
for everyone you
battle.
Be kind,
meet is fighting a hard
IAN MACLAREN
”



care | FALL/WINTER 2022 39
St. Albert Trail Place, 13163 - 146 Street Edmonton, Alberta T5L 4S8 Telephone (780) 484-8886 Toll-Free 1-800-661-5877 Fax (780) 484-9069
Professional Development profdev@clpna.com
ISSN 1920-633X CARE
Publications Mail Agreement Number 40050295
Return Undeliverable Canadian Addresses To: St. Albert Trail Place, 13163 - 146 Street Edmonton, Alberta T5L 4S8 email: care@clpna.com www.clpna.com
www.CLPNA.com
Advice?
Need
Nursing Practice practice@clpna.com
Make a Complaint Governance Documents Public Registry of LPNs
Information & Services V Study with CLPNA Courses

Co-authored by AHS Harm Reduction Services and CLPNA staff
Co-authored by AHS Harm Reduction Services and CLPNA staff















